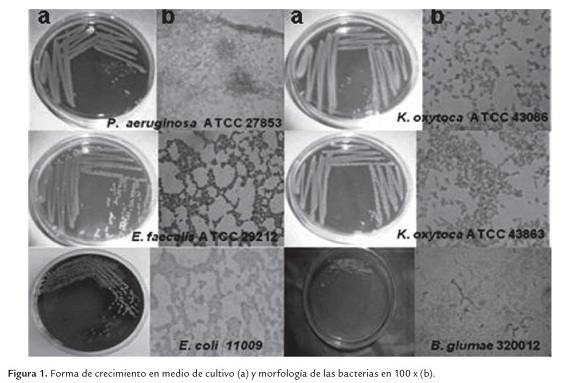

Serviços Personalizados
Journal
Artigo
Indicadores
-
Citado por SciELO -
Acessos
Links relacionados
-
Citado por Google -
Similares em
SciELO -
Similares em Google
Compartilhar
Revista Colombiana de Biotecnología
versão impressa ISSN 0123-3475
Rev. colomb. biotecnol v.14 n.1 Bogotá jan./jun. 2012
ARTÍCULO CORTO
Actividad antibacteriana de extracto de hojas de Melia azedarach L.
Antibacterial activity of leaf extract Melia azedarach L.
Johanna Norela Rojas Sierra1, Alexander Francisco Pérez Cordero2, Jose Gregorio Martínez Avilez3, Jorge Ulises Mieles Galindo3.
1 Biologa, MSc en Microbiología, Universidad de Sucre. Grupo de Bioprospección Agropecuaria. johanna.rojas@unisucre.edu.co
2 Ingeniero Agrónomo, MSc y P.hD en Microbiología, Universidad de Sucre. Grupo de Bioprospección Agropecuaria. alexander.perez@unisucre.edu.co
3 Biólogos, Universidad de Sucre. Campo Universitario AA 406, Sincelejo, Sucre, Colombia.
Recibido: octubre 25 de 2011 Aprobado: junio 27 de 2012
Resumen
El trabajo tuvo como objetivo evaluar la actividad antibacteriana de extractos de hojas de Melia azedarach L. sobre seis bacterias patógenas. Inicialmente mediante extracción por el método Soxhlet se obtuvo extracto total en etanol y a partir de éste se prepararon fracciones líquido-líquido con éter de petróleo y acetato de etilo. El extracto total y las dos fracciones fueron diluidos a diferentes concentraciones (ppm) para evaluar in vitro su actividad antibacteriana. Las bacterias de mayor susceptibilidad fueron las patógenas de humanos Enterococcus faecalis, Escherichia coli, Pseudomonas aeruginosa y Klebsiella oxytoca, en relación a la fitopatógena Burkholderia glumae quien mostró resistencia a todos los tratamientos. Las bacterias patógenas fueron más susceptibles a la fracción éter de petróleo a concentración mínima de 25 ppm. El screen fitoquímico de la planta indicó presencia de metabolitos secundarios tipo alcaloides, terpenos/esteroles, saponinas, taninos y antocianinas. Estos resultados evidencian el posible uso de M. azederach como alternativa de control biológico sobre las bacterias analizadas.
Palabras clave: bacterias, patógenas, inhibición, extractos.
Abstract
The work was objective to evaluate the antibacterial activity of extracts from leaves of Melia azedarach (L) on six pathogenic bacteria. Total ethanol extract was obtained initially by extraction with method Soxhlet and from this prepared liquid-liquid fractions with petroleum ether and ethyl acetate. The total extract and the two fractions were diluted at different concentrations (ppm) to evaluate its antibacterial activity in vitro. More susceptible bacteria were the pathogenic human Enterococcus faecalis, Escherichia coli, Pseudomonas aeruginosa and Klebsiella oxytoca, in relation to the plant pathogen Burkholderia glumae who showed resistance to all treatments. Pathogenic bacteria were more susceptible to the fraction of petroleum ether to the minimum concentration of 25 ppm. Screen plant phytochemical indicated presence of secondary metabolites type alkaloids, terpenes/sterols, saponins, tannins and anthocyanins. These results demonstrate the potential use of M. azederach as biological control alternatively on analysed bacterial.
Key words: bacteria, pathogenic, inhibition, extract.
Introducción
Generalmente las infecciones que se presentan en América latina son ocasionadas por bacterias patógenas; lo que se ha convertido en un problema de salud pública en los países en vía de desarrollo donde las condiciones de vida son precarias. La mayoría de estas bacterias originan enfermedades que se transmiten entre la población. P. aeruginosa es un patógeno oportunista de importancia clínica, causante de infecciones del tracto urinario, vías respiratorias, dermatitis, infecciones de tejidos blandos, bacteriemia, infecciones óseas y articulares, infecciones gastrointestinales, infecciones en pacientes con quemaduras graves, cáncer y en pacientes inmunodeprimidos (Todar, 2008). E. faecalis, causa infecciones nosocomiales, además de ser resistentes a un sin número de agentes antimicrobianos (Morrinson et al., 1997). K. oxytoca, patógena oportunista que causa enfermedades graves como septicemia, neumonía, infecciones del tracto urinario e infecciones de tejidos blandos (Kovtunovych et al., 2003). E. coli, anaeróbica facultativa del tracto intestinal del hombre y de algunos animales, algunas especies causan infección urinaria, septicemia, meningitis o enfermedad diarreica (Vidal et al., 2007). B. glumae, agente causal de la enfermedad conocida como añublo bacterial de la panícula del arroz, la cual se ha convertido en una enfermedad de importancia en los últimos años, debido a las pérdidas económicas que ocasiona al sector agrícola (Pérez et al., 2008).
Teniendo en cuenta la anterior problemática, un reto que se debe asumir es el aprovechamiento de la biodiversidad como potencial biológico en beneficio de la sociedad (Lizcano y Vergara, 2008), realizando estudios que permitan el descubrimiento de moléculas bioactivas novedosas, las cuales pueden ser halladas a partir de fuentes naturales como los vegetales. El aumento de la resistencia de los microorganismos a los antimicrobianos sintéticos utilizados convencionalmente, ha creado la necesidad de buscar nuevas sustancias que permitan controlar enfermedades asociadas a microorganismos que mejoren la calidad de vida de la población (Lizcano y Vergara, 2008; Petrera y Coto, 2009).
En el departamento de Sucre, existe una amplia diversidad de especies vegetales, las cuales han sido solo estudiadas desde el punto de vista ecológico y botánico, siendo escasa o nula la información química o farmacológica de estas especies; de tal manera que se desconoce su posible potencial biológico en la inhibición de microorganismos causantes de enfermedades. Por esta razón se hace necesario aprovechar especies vegetales, como M. azedarach, para determinar compuestos químicos y sustancias biológicamente activas con efectos antimicrobianos que permitan controlar microorganismos de gran importancia, especialmente para la medicina y agricultura.
Materiales y métodos
Material vegetal
El material vegetal de M. azedarach, se recolectó en el municipio de Sincelejo, departamento de Sucre. Unas muestras fueron utilizadas para su respectiva clasificación taxonómica en el Herbario Nacional de Colombia y las otras para el proceso de obtención del extracto.
Proceso de extracción
Para la obtención del extracto vegetal se empleó la metodología propuesto por Gualtieri et al., (2008) con algunas modificaciones. Las hojas fueron previamente secadas a temperatura ambiente por 8 días, se picaron y se utilizaron 1000 g, las cuales fueron sometidas a extracción con etanol al 97% en equipo Soxhlet a 60 0C-80 0C durante 6 horas, concentrándose en rotaevaporador a 60 °C al vacío hasta sequedad. Después de obtener el extracto etanólico, se realizó un fraccionamiento líquido-líquido con éter de petróleo y acetato de etilo, obteniéndose las fracciones correspondientes (Ávila et al., 2006). Para evaluar la actividad antibacteriana, el extracto etanólico total seco y sus diferentes fracciones fueron diluidos con dimetilsulfóxido para preparar concentraciones de 1, 5, 10, 25, 50 y 75 ppm.
Bacterias evaluadas
Las bacterias evaluadas fueron: E. coli 11009 (aislada de paciente hospitalario), P. aeruginosa ATCC 27853, K. oxytoca ATCC 43863, K. oxytoca ATCC 43086, E. faecalis ATCC 29212 y B. glumae 320012 (CIAT).
Evaluación in vitro de actividad antibacteriana
Para la evaluación de actividad antibacteriana con el extracto etanólico total seco y sus diferentes fracciones sobre las bacterias se utilizó el método de difusión en disco sobre agar, realizando siembra de las bacterias purificadas en medio sólido por medio de la técnica de Kirby-Bauer en agar Mueller-Hinton. La concentración de todas las bacterias fue de 108 UFC/ml. Los discos estériles de papel filtro fueron sumergidos por 24 horas en las diferentes concentraciones del extracto etanólico total y las fracciones E. petrol y AcOEt, transcurrido este tiempo, se depositaron sobre la superficie del medio de cultivo inoculado. Las placas se incubaron a 30 ºC por 24 horas (Cuellar y Hussein, 2009). Para los experimentos se utilizó un control positivo con gentamicina 120 mg/mL y negativo dimetilsulfóxido. Los ensayos se realizaron por triplicado y la evaluación se hizo por medición del diámetro de las zonas de inhibición de crecimiento alrededor de los discos (mm). La eficiencia de la actividad antibacteriana fue comparada con el control positivo.
Identificación cualitativa de metabolitos secundarios
La comprobación de los diferentes tipos de metabolitos secundarios se realizó por medio de pruebas de coloración y reacciones estandarizadas que indicaron la presencia de compuestos químicos específicos. Se hizo determinación de flavonoides, taninos, triterpenos/esteroles, quinonas, saponinas, alcaloides y antocianinas (Contreras y Cortéz, 2007).
Análisis espectroscopia de infrarrojo (ir)
Los análisis de las muestras de caracterización o identificación del extracto etanólico y las fracciones éter de petróleo y acetato de etilo, se realizaron en la Universidad de Cartagena. Se empleó un espectrofotómetro de infrarrojo (FTIR)-84005 FOURIER TRANSFORM marca SHIMADZU, en la región 4000-400 cm-1. Se realizó el procedimiento para muestras en disco sólido- NaCl (Skood et al., 2001).
Análisis estadístico
Para establecer relación de la actividad antibacteriana (inhibición) del extracto de hojas de M. azedarach, en función a las diferentes variables tales como: extractos, concentraciones y bacterias, se realizó un ANOVA multifactorial. Se realizaron pruebas para determinar qué factores tuvieron un efecto estadísticamente significativo sobre inhibición. Se evaluó la significancia de las interacciones entre los factores, las cuales fueron evidenciadas de acuerdo a los resultados de las pruebas-f obtenida mediante ANOVA lo que permitió identificar los factores de mayor significancia. Los análisis fueron realizados mediante el programa estadístico R (R development core team, 2009).
Resultados y discusión
Identificación taxonómica
La especie vegetal utilizada en el presente estudio fue identificada como M. azedarach, de la familia Meliaceae. Un ejemplar se encuentra en el Herbario Nacional de Colombia (voucher 546006)
Bacterias
En la figura 1ase observan la forma de crecimiento de cada una de las bacterias patógenas en el medio agar sangre y en el caso de B. glumae en medio King B. En la figura 1b se aprecia la morfología (100 x) mediante la técnica de tinción de Gram.
Actividad antibacteriana
En la tabla 1 se muestra los resultados del análisis de varianza (ANOVA) multifactorial de la actividad antibacteriana (mm) en función a las variables extractos, concentración y bacterias. Los resultados mostraron diferencia altamente significativa para todas las variables analizadas, debido a que el valor p en todos los casos (0.0000) fue menor al nivel de significancia (0.05). Este resultado permite evidenciar la actividad de los extractos y sus diferentes concentraciones sobre la inhibición producida sobre las bacterias patógenas evaluadas.
Para visualizar la diferencias estadísticas encontrada en la tabla anterior, en relación al extracto total etanólico y fracciones, se procedió a realizar grafico boxplot (figura 2), observándose que la fracción de E. petrol presentó la mayor actividad sobre las bacterias patógenas (±3.5-6-0 mm), seguida de AcOEt (±1.5-5.0 mm) y extracto etanólico total (±0-4.0 mm).
En la figura 3, se muestran los resultados obtenidos de las diferentes concentraciones evaluadas sobre E. coli, P. aeruginosa, K. oxytoca ATCC 43863 y ATCC 43086, E. faecalis y B. glumae. En general las bacterias fueron susceptibles a medida que las concentraciones fueron aumentando, es así como en la concentración de 1,0 ppm (T1), la actividad antibacteriana (halo o zona de inhibición) presentó valores menores a 4 mm; las concentraciones de 5.0 ppm (T2) y 10.0 ppm (T3) los rangos de actividad fueron muy similares; a partir de la concentración de 25 ppm (T4), se observa mayor actividad antibacteriana sobre las diferentes bacterias patógenas. De acuerdo a los resultados mostrados de los tratamientos T4, T5 y T6, se puede inferir que para este estudio la concentración mínima inhibitoria es a partir de 25 ppm.
En la figura 4, se muestran los resultados gráficos del análisis por Boxplot para cada una de las bacterias evaluadas. Se observa que las bacterias patógenas de humanos (K. oxytoca ATCC 43863 y ATCC 43086, P. aeruginosa, E. coli, E. faecalis) fueron las más susceptibles, a diferencia de la resistencia mostrada por la bacteria fitopatógena B. glumae. Los metabolitos presentes en estos extractos se convierten en alternativas de control, debido a que estas bacterias durante los últimos años, han aumentado su resistencia frente a los antibióticos comúnmente empleados, generando un problema de salud pública (Beaber et al., 2004).
Estos resultados potenciales de actividad antimicrobiana de Melia, coinciden con los reportados por otros autores, quienes observaron efecto sobre las bacterias E. faecalis, E. coli y P. aeruginosa (Ramya et al., 2009; De Araujo et al., 2009). Otros trabajos realizados por Khan et al., (2001) con extractos de hoja de M. azedarach encontraron actividad del extracto etanólico sobre E. coli y con las fracciones de éter de petróleo y acetato de etilo sobre E. coli y P. aeruginosa. Es necesario resaltar los resultados de la bacteria fitopatógena, para la cual ninguno de los tratamientos evaluados y aún el antibiótico tuvo efecto inhibitorio (figura 5).
El antibiótico gentamicina, mostró eficiencia en todos los ensayos, sin embargo al comparar sus resultados con los tratamientos evaluados, se puede evidenciar que estos compuestos orgánicos biológicamente activos, representan una alternativa eficaz para disminuir la resistencia que en los últimos años han desarrollado los microorganismos frente a los antibióticos (Borboa-Flores et al., 2010). El dimetilsulfóxido utilizado para preparar las concentraciones del extracto etanólico total y las fracciones no presentó ningún tipo de interferencia en los resultados obtenidos, puesto que no mostró actividad inhibitoria en los ensayos (figura 5).
Identificación cualitativa de metabolitos secundarios
El análisis fitoquímico realizado al extracto en etanol de las hojas frescas de M. azedarach permitió determinar la presencia de metabolitos secundarios tipo alcaloide, terpenos/esteroles, saponinas, taninos y antocianina (tabla 2). La detección de estos compuestos coinciden con lo reportado por otros autores dentro de la fitoquímica de la especie (Khan et al., 2001; De Araujo et al., 2009).
La producción de metabolitos secundarios le ha permitido a las plantas protegerse del ataque de diversos microorganismos patógenos. Los mecanismos de acción de estos compuestos orgánicos producidos por las plantas son variables; es así como la toxicidad de los fenoles se atribuye a la oxidación de compuestos; los terpenos están involucrados en el rompimiento de la membrana a través de los compuestos lipofílicos; se ha postulado que los alcaloides se intercalan en la doble cadena del ADN o pueden penetrar la membrana plasmática combinándola y precipitando las proteínas protoplasmáticas y desnaturalizándolas (Borboa-Flores et al., 2010; Aguas y Morales, 2006). Así mismo las lectinas y polipéptidos pueden formar canales iónicos en la membrana microbiana (Borboa-Flores et al., 2010).
Análisis espectroscopia de infrarrojo (ir)
Las señales de los espectros infrarrojos del extracto etanólico y las fracciones éter de petróleo y acetato de etilo obtenidos a partir de la muestra de hojas secas de M. azedarach son similares en presencia de grupos funcionales, tales como el estiramiento de compuestos alquinos (2340, 2364 y 2345 cm-1), cadena alifática tipo alcano (2900 y 2925 cm-1) y estiramiento de grupo aldehído (1725, 1731 y 1740 cm-1) (figura 6). La fracción acetato de etilo presentó un estiramiento en 3750 cm-1, propio de compuestos amina primaria (NH2) constituyentes de los alcaloides, los cuales están relacionados con algunos efectos antibacterianos (Mercado y Vargas, 2003).
Los resultados de la actividad inhibitoria mostrada con la fracción éter de petróleo, posiblemente se explica debido a que este solvente separó por afinidad, principios activos del extracto total etanólico, como triterpenoides y esteroles, los cuales se consideran responsables del efecto inhibitorio sobre las bacterias de K. oxytoca y P. aeruginosa (figura 2) (Adnan,y Al Rubae, 2009). Así mismo; la mayoría de los triterpenoides y esteroles conocidos son solubles en solventes orgánicos de baja polaridad, como el éter de petróleo y menos solubles en alcoholes de bajo peso molecular (Martínez, 2002). Es probable que el extracto etanólico presentó menor inhibición con respecto a las dos fracciones mencionadas, por constituir una mezcla compleja de metabolitos, los cuales pueden ejercer un efecto antagónico estando en el extracto total y así impedir que se pueda presentar una respuesta antibacteriana eficaz (Osorio, 2009).
Conclusiones
Al comparar los resultados del extracto etanólico y las diferentes fracciones, se observó mayor actividad inhibitoria de la fracción éter de petróleo sobre las bacterias patógenas de humanos. Convirtiéndose estos resultados como un posible potencial biológico, que sugiere realizar otros estudios donde se identifique los compuestos específicos que producen los efectos inhibitorios. Un aspecto para resaltar en este estudio fue la resistencia de la bacteria fitopatógena frente a todos los tratamientos utilizados y al control positivo, situación ésta que obliga a seguir evaluando otras especies vegetales.
Agradecimientos
Los autores expresan sus agradecimientos, a los laboratorios de fitoquímica y microbiología de la Universidad de Sucre, a la Universidad de Cartagena y en especial a la profesora Johana Rodríguez.
Referencias bibliográficas
1 Aguas, E; Morales, X. 2006. Química preliminar y evaluación de la actividad antibacterial del extracto etanólico del tallo de Matelea maritima (Asclepidiaceae). Trabajo de grado [Biólogo con Énfasis en Biotecnología]: Sincelejo: Universidad de Sucre, Facultad de Educación y Ciencias, Departamento de Biología, p43. [ Links ]
2 Adnan., Al Rubae. 2009. The Potential Uses of Melia azedarach L as Pesticidal and Medicinal Plant, Review. American-Eurasian.Journal of Sustainable Agriculture. 3(2): 185-194. [ Links ]
3 Ávila L., Baquero E., Viña A., Murillo E. 2006. Actividad antibacteriana de Diplostephium tolimense cuatrec.(Asteraceae) frente a Staphylococcus aureus. Revista de la Facultad de Química farmacéutica.13(1):55-60. [ Links ]
4 Beaber J., Hochhut B., Waldor M. 2004. SOS response promotes horizontal dissemination of antibiotic resistance genes. Nature. 427:72-74. [ Links ]
5 Borboa-Flores J, Rueda-Puente E., Acedo-Félix E., Ponce J., Cruz-Villegas M., García-Hernández J., Ortega-Nieblas, M. 2010. Evaluación de la actividad antibacteriana in vitro de aceites esenciales contra Clavibacter michiganensis subespecie michiganensis. Tropical and Subtropical Agroecosystems.12:539 - 547 [ Links ]
6 Contreras, E; Cortéz, D. 2007. Tamizaje fitoquímico preliminar de la raíz seca de Rauvolfia viridis Roem et Schult (Apocinaceae) y evaluación in vitro de la actividad antiofídica frente al veneno de Bothops asper.Trabajo de grado [Biólogo con Énfasis en Biotecnología]: Sincelejo: Universidad de Sucre, Facultad de Educación y Ciencias, Departamento de Biología. [ Links ]
7 Cuellar A., Hussein R. 2009. Evaluation of the yield and the antimicrobial activity ofthe essential oils from: Eucalyptus globulus, Cymbopogon citratus and Rosmarinus officinalis in mbarara district (Uganda).Revista Colombiana de Ciencia Animal. 1(2): 240-249. [ Links ]
8 De araújo S, Teixeira M., Dantas T., Melo V., Lima F., Ricarte A., Costa E., Miranda A. 2009. Artigo de revisão Usos potenciais de Melia azedarach l. (Meliaceae): um levantamento. Arquivos do Instituto Biologico. 76(1):141-148. [ Links ]
9 Gualtieri M., González M., Contreras K., Noguera M., Uzcátegui E., Villasmil S., Villalta R. 2008. Evaluación de la actividad antimicrobiana de los extractos etanólicos de Azadirachta indica. Revista del Instituto Nacional de Higiene Rafael Rangel. 39 (2):12-16. [ Links ]
10 Khan M.R., Kihara M., Omoloso A.D. 2001. Antimicrobial activity of Horsfieldia helwigii and Melia azedarach. Fitoterapia 72: 423-427. [ Links ]
11 Kovtunovych G., Lytvynenko T., Negrutska V., Lar O., Brisse S., Kozyrovska N. 2003. Identification of Klebsiella oxytocausing a specific PCR assay targeting the polygalacturonase peh Xgene. Research in Microbiology. 154(8):587-592. [ Links ]
12 Lizcano, A; Vergara, J. 2008. Evaluación de la actividad antimicrobiana de los extractos etanólicos y/o Aceites Esenciales de las especies vegetales, Valeriana pilosa, Hesperomeles ferruginea, Myrcianthes rhopaloies y Passiflora manicata frente a microorganismos patógenos y fitopatógeno. Trabajo de grado (Microbiología Industrial): Bogotá D.C.: Pontificia Universidad Javeriana, Facultad de Ciencias, Carrera de Microbiología Industrial. Disponible en http://www.javeriana.edu.co/biblos/tesis/ciencias/tesis151.pdf. [ Links ]
13 Martínez, A. 2002. Universidad de Antioquia Esteroles. Curso de Farmacognosia y Fitoquímica (en línea). Disponible en http://farmacia.udea.edu.co/~ff/esteroles2001.pdf. [ Links ]
14 Mercado, A; Vargas, C. 2003. Evaluación de la Actividad Antifúngica y Antibacteriana del Extracto Etanólico total de las hojas de Pedilanthus tithymaloides L poit (Ultimorrial).Trabajo de grado (Biólogo con Énfasis en Biotecnología): Sincelejo: Universidad de Sucre, Facultad de Educación y Ciencias, Departamento de Biología. [ Links ]
15 Morrison D., Woodford N., Cookson B. 1997.Enterococci as emerging pathogens of humans. Journal of AppliedMicrobiology. 83:895-995. [ Links ]
16 Osorio E. 2009. Universidad de Antioquia Aspectos Básicos de Farmacognosia. Curso de Farmacognosia y Fitoquímica. Disponible en: http://farmacia.udea.edu.co/~ff/Farmacognosia.pdf. [ Links ]
17 Pérez C., Saavedra E., López P., Cardona G. 2008. Medidas preventivas sobre la bacteria Burkholderia glumae en el cultivo de arroz. Revista Arroz. 56:22-26. [ Links ]
18 Petrera E., Coto C. 2009. Therapeutic Effect of Meliacine, An Antiviral Derived from Melia azedarachL., in Mice Genital Herpetic Infection. Phytotherapy Research. 23(12): 1771-1777. [ Links ]
19 R Development core team R: A 2009. Language and Environment for Statistical computing, R 397 Foundation for Statistical Computing. Disponible en: http://www.R-398 project.org. [ Links ]
20 Ramya S., Jepachanderamohan P., Alaguchamy N., Kalayanasundaram M., Jayakumararaj R. 2009. In vitro Antibacterial Prospective of Crude Leaf Extracts of Melia azedarach Linn against Selected Bacterial Strains. Ethnobotanical Leaflets. 13:254-58. [ Links ]
21 Skood, D; Holler, F; Nieman, T. 2001. Principio de Análisis Instrumental 5ed. España: Editorial Mc Graw [ Links ]
22 Todar K. Pseudomonas aeruginosa 2008. En línea: Online textbook of bacteriology. http://www.textbookofbacteriology.net [citado en 24 de febrero de 2010] [ Links ]
23 Vidal J., Canizales-Roman A., Gutiérrez-Jiménez J., Navarro-García F. 2007. Patogénesis molecular, epidemiología y diagnóstico de Escherichia coli enteropatógena. Salud Pública de México. 49(5): 376-386. [ Links ]